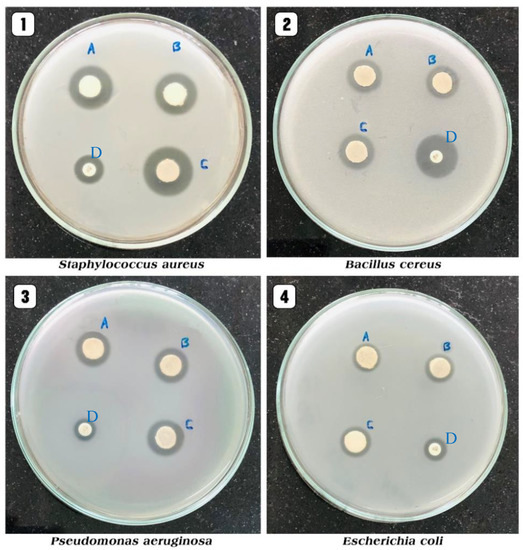

Abstract
Nanoparticles (NPs) exhibit distinct features compared to traditional physico-chemical synthesis and they have many applications in a wide range of fields of life sciences such as surface coating agents, catalysts, food packaging, corrosion protection, environmental remediation, electronics, biomedical and antimicrobial. Green-synthesized metal NPs, mainly from plant sources, have gained a lot of attention due to their intrinsic characteristics like eco-friendliness, rapidity and cost-effectiveness. In this study, zinc oxide (ZnO) NPs have been synthesized employing an aqueous leaf extract of Pelargonium odoratissimum (L.) as a reducing agent; subsequently, the biosynthesized ZnO NPs were characterized by ultraviolet-visible spectroscopy (UV-Vis), dynamic light scattering (DLS), Fourier transform infrared (FTIR) spectroscopy, X-ray diffraction (XRD), field emission scanning electron microscopy (FESEM) and energy-dispersive X-ray spectroscopy (EDX), high-resolution transmission electron microscopy (HRTEM) and selected area electron diffraction (SAED). Moreover, aqueous plant leaf extract was subjected to both qualitative and quantitative analysis. Antioxidant activity of ZnO NPs was assessed by DPPH assay, with varying concentrations of ZnO NPs, which revealed scavenging activity with IC50 = 28.11 μg mL−1. Furthermore, the anti-bacterial efficacy of the green synthesized ZnO NPs against four foodborne pathogenic bacterial strains was examined using the disk diffusion assay, and Staphylococcus aureus (ATCC 8095), Pseudomonas aeruginosa (ATCC10662) and Escherichia coli (ATCC 25922) were found to be the most sensitive against biosynthesized ZnO NPs, whereas the least sensitivity was shown by Bacillus cereus (ATCC 13753). The anti-inflammatory effect was also evaluated for both ZnO NPs and the aqueous leaf extract of P. odoratissimum through the human red blood cells (HRBC) membrane stabilization method (MSM) in vitro models which includes hypotonicity-induced hemolysis. A maximum membrane stabilization of ZnO NPs was found to be 95.6% at a dose of 1000 μg mL−1 compared with the standard indomethacin. The results demonstrated that leaf extract of P. odoratissimum is suitable for synthesizing ZnO NPs, with antioxidant, antibacterial as well as superior anti-inflammatory activity by improving the membrane stability of lysosome cells, which have physiological properties similar to erythrocyte membrane cells and have no hemolytic activity. Overall, this study provides biosynthesized ZnO NPs that can be used as a safe alternative to synthetic substances as well as a potential candidate for antioxidants, antibacterial and anti-inflammatory uses in the biomedical and pharmaceutical industries.
1. Introduction
Nanotechnology is one of the most quickly evolving fields, potentially forming and underpinning a wide range of technological and biotechnological advancements; as a result, it is seen as the century’s oncoming industrial revolution [1]. Nanotechnology has been used in different industrial and academic areas, including chemistry, agriculture, biology, medicine, electronics, information technology and physics [2,3,4]. Nanomaterials possess great potential in various fields of science due to their excellent physico-chemical and biological characteristics over bulk materials [5]. Nanoparticles (NPs) have the unique property of having a high surface-to-volume ratio [6], which means that they are more appropriate candidates for application-oriented performance (e.g., photocatalysis, cosmetics, gas sensing, energy reservoirs, electronics, packaging and environmental remediation) and encourages their incorporation into a wide range of commercial products, biotechnology and biomedical applications [7,8,9,10,11,12,13].
Among the large variety of NPs available, metal oxide (MO) NPs are thought to be the most promising because they have distinctive physical, chemical, and biological properties like solubility, chemical stability, and adhesiveness [8]. Additionally, the utilization of harmful compounds for reduction and as a capping agent in the nanoparticle synthesis process causes a variety of adverse effects on the flora life as well as the environment and the living system toxicity. As a result, plant extracts (PEs) are therefore a more promising tool for the easy synthesis of MO NPs through the green route, because this approach is eco-friendly, non-toxic, low cost, environmentally compatible and easy to apply. Additionally, the resultant particles are biocompatible and free of toxic stabilizers compared to classical chemicals. Basically, PEs contain a variety of active biomolecules that aid to reduce and stabilize NPs [6,12].
Zinc oxide (ZnO) is one of the very promising inorganic oxides that has recently attracted the attention of many scientists for the biosynthesis of NPs due to its unique properties and multiple applications such as drug delivery, solar cells, photocatalytic degradation and personal care products like sunscreens and cosmetics [14,15,16,17,18,19]. Based on earlier reports in the literature, ZnO NPs have been biosynthesized from several plant extracts such as Cassia auriculata [20], Aloe vera [13,21], Duranta erecta [22], Cinnamomum verum [23], Bauhinia tomentosa [24], Vitex trifolia [25], Moringa oleifera [26], Azadirachta indica [27,28], Artocarpus gomezianus [29] and Olea europaea [30]. In biological systems, the overproduction of highly reactive radical species (HRRS) causes oxidative stress, which has been observed in several diseases, i.e., cancer, diabetes, cardiovascular disease, and arthritis [31]. All biosystems depend heavily on antioxidants to function correctly. As a result, there is an urgent need to search for innovative and safe antioxidants produced from natural sources, which are more effective and less toxic. Additionally, the widespread use of antibacterial and anti-inflammatory drugs has caused resistance, the appearance of new pathogenic strains resistant to antibiotics [32] and chronic and acute toxicities in several human physiological systems, particularly the immune system. As a result, searching for new, effective antibacterial and anti-inflammatory drugs that can effectively combat drug-resistant bacteria is necessary and does not cause immunosuppression. Biosynthesized NPs have been proposed as an alternate potential approach to address these problems [33]. Pelargonium odoratissimum (L.) aqueous leaf extract (ALE) was utilized in the present study, for the biosynthesis of ZnO NPs as this is the first report on the use of this plant’s leaves for the green synthesis of NPs. Pelargonium odoratissimum (L.) known as “Apple Geranium” is a perennial and relatively flat-growing shrublet that belongs to the family Geraniaceae, very commonly grown locally in Egypt and is widely utilized for its health benefits [34]. Essential oils of Pelargonium spp. are in considerable demand in the pharmaceutical, perfumery, and cosmetic industries. Additionally, some reports revealed that essential oils obtained from a variety of Pelargonium spp. possess excellent antioxidant, antibacterial and antifungal properties [35,36,37,38]
The aerial parts of this Pelargonium spp. are used in traditional medicine for the treatment of wound healing, debility, gastrointestinal disorders (i.e., diarrhea and dysentery), hemorrhage, skin complaints, neuralgia and throat infections due to their various phytochemical constituents such as phenolics, flavonoids, terpenes, saponins and essential oils [39], which can contribute to their biological activities and facilitate the biosynthesis of NPs by employing them as reducing, capping and stabilizing agents.
Despite the widespread use of Pelargonium species as therapeutic agents, to date, there have been no data on their use for green synthesis of NPs, antioxidant, antibacterial and anti-inflammatory effects from Pelargonium odoratissimum leaf extract.
The aim of this study was to explore the application of P. odoratissimum ALE as a capping and reducing agent for the biosynthesis of ZnO NPs. The biosynthesized ZnO NPs were characterized and confirmed by various spectroscopic and microscopic techniques, i.e., UV-Vis spectroscopy, FTIR, XRD, DLS, HR-TEM, FE-SEM and EDX, in addition, to evaluate the antioxidant effects, as well as the antibacterial activities against some food-borne pathogens strains beside evaluating the anti-inflammatory activities of both ZnO NPs and the ALE of P. odoratissimum.
2. Materials and Methods
2.1. Chemicals
Gallic acid, rutin, 1,1-diphenyl-2-picrylhydrazyl (DPPH, ≥99%), Folin–Ciocalteu’s reagent, L-ascorbic acid (Sigma-Aldrich, St. Louis, MO 63103, USA), aluminum chloride anhydrous (Fluka, Buchs, Switzerland), sodium carbonate (>99%), zinc acetate dihydrate (Advent Chembio PVT. LTD, Mumbai, India), Luria-Bertani (LB) broth medium (Himedia, Mumbai, India) gentamycin (Tody Laboratories Int., 22nd Vadul Moldovei Street, Bucharest, Romania). All chemicals used in this study were of analytical grade.
2.2. Plant Collection and Processing
Fresh leaves of P. odoratissimum (L.) were collected from the Botanical Garden of Fayoum University, Fayoum, Egypt, in March 2021. The taxonomic identification of the plant was identified by Mrs. Therese Labib, Head of the Taxonomy specialists at El-Orman Botanical Garden, Cairo, Egypt. A voucher specimen with number 126 was deposited in the herbarium of the Biochem. Dept. Fac. Agric., Fym. Univ., Fym., Egypt. The leaves were completely air dried in the shade before being ground into a fine powder in a lab mill and sieved using a 24 mesh sieve. The powdered leaves were maintained in an air-tight container at room temperature (28 ± 2 °C) and kept away from light until use.
2.3. Preparation of P. odoratissimum Leaf Extract
The air-dried powder (20 g) of P. odoratissimum leaves was taken and immersed in 400 mL of deionized water (dH2O). The extraction process was performed via the ultrasonic-assisted solvent extraction (UASE) method [40] by placing the conical flask in a Probe Sonicator homogenizer (Benchmark Scientific, USA, 150 W, 25 kHz) at room temperature (35 ± 2 °C) for 30 min. The solvent (d.H2O) and powder layer were filtered using muslin cloth first and then Whatman filter paper No.1. The filtrate solution of P. odoratissimum leaf extract was kept in a refrigerator to be utilized for further use.
2.4. Qualitative Phytochemical Screening
The detection of various phytoconstituents present in the ALE of P. odoratissimum was carried out using the standard phytochemical methods [41,42,43].
2.5. HPLC-Analysis
The HPLC analysis was carried out using an Agilent 1260 series. The separation was performed using Eclipse C18 column (4.6 mm × 250 mm i.d., 5 μm). The mobile phase consisted of water (A) and 0.05% trifluoroacetic acid (TFA) in acetonitrile (B) at a flow rate of 0.9 mL/min. The mobile phase was programmed consecutively in a linear gradient as follows: 0 min (82% A); 0–5 min (80% A); 5–8 min (60% A); 8–12 min (60% A); 12–15 min (82% A); 15–16 min (82% A) and 16–20 (82%A). The multi-wavelength detector was monitored at 280 nm. The injection volume was 5 μL for each of the sample solutions. The column temperature was maintained at 40 °C.
2.6. Estimation of Total Phenolic and Flavonoid Contents (TPC and TFC)
The determination of both TPC as mg gallic acid equivalents (GAE) mg GAE/g plant extract) and TFC as mg rutin equivalents (RE)/g plant extract were performed spectrophotometrically by the Folin-Ciocalteu reagent [44] and aluminum chloride methods [45] respectively.
2.7. Green Synthesis of ZnO Nanoparticles
After heating twenty milliliters of P. odoratissimum leaf extract at 50 °C for 10 min, fifty milliliters of 0.1 M zinc acetate dihydrate (Zn(CH3COO)2·2H2O) (1.095 g of zinc acetate dihydrate was dissolved in 50 mL of d.H2O) was added drop-by-drop to it under stirring at 800 rpm that resulted in cream-colored zinc hydroxide precipitate formation. For the complete reduction in zinc hydroxide, the reaction mixture was left for 30 min. Then the precipitate was centrifuged (Sigma Laborzentrifugen 2k15, Osterode, Germany) at 16,000 rpm for 10 min at 4 °C by dH2O followed by ethanol repeatedly in order to remove the impurities. The precipitate was dried overnight in an oven at 100 °C. The obtained dried powder was calcined in a muffle furnace at 600 °C for 2 h and the white powder of ZnO NPs was obtained after calcination as shown in Figure 1. The resulted powder was used for characterization.

Figure 1.
Represent (pictorial) the synthesis of ZnO NPs via P. odoratissimum ALE.
2.8. Characterization Methods of ZnO NPs
2.8.1. UV-Vis Spectroscopy
In order to study the optical characteristics of green synthesized ZnO NPs, a known amount of ZnO NPs (0.05 g) was dispersed in 5 mL of ethanol (96%). The absorption spectrum was recorded by using a UV-Vis (U-2900) double beam spectrophotometer (Hitachi, Tokyo, Japan) in between a wavelength scan of 200–800 nm.
2.8.2. Dynamic Light Scattering (DLS)
A particle size analyzer (Zetasizer V 2.2, Worcestershire, Malvern, UK) was utilized to determine the particle size distribution (PSD) of ZnO NPs obtained using ALE. The zeta potential of ZnO NPs was carried out in the water as a dispersant through a Zeta sizer (V 2.3, Worcestershire, Malvern, UK) to identify the stability of the synthesized NPs.
2.8.3. Fourier Transform Infra-Red Spectroscopy (FTIR)
FTIR analysis (Bruker, Berlin, Germany) was employed to identify the functional groups (FGs) involved in biosynthesized ZnO NPs. At a wavelength of 4000–400 cm−1, the FTIR spectra were scanned with a resolution of 4.0 cm−1.
2.8.4. X-ray Diffraction (XRD)
The crystalline structure of ZnO NPs was analyzed by an X-ray diffractometer (Bruker D8 DISCOVER, Bruker, Germany) with Cu-Kα radiation (λ = 1.54060 Angstrom). The relative intensity data were collected over a 2θ range of 5°–80°, 2θ values and relative intensities (I/Io) were determined from the chart, and the minerals of core materials were identified with JCPDS carts.
2.8.5. Field Emission-Scanning Electron Microscopy (FE-SEM)
The topography and surface morphology of the biosynthesized ZnO NPs were examined using FE-SEM (Carl- ZEISS Sigma 500 VP, Sigma, Osterode, Germany) equipped with an energy dispersive X-ray spectrometer (EDX, Bruker, Germany) for the element composition present in the powder of ZnO NPs. A portion of the sample was set on a carbon-coated copper (CCC) grid, and the film on the FE-SEM grid was then dried by fixing it under gold for 5 min.
2.8.6. High-Resolution Transmission Electron Microscopy (HRTEM)
The shape and size distribution of powdered ZnO NPs were studied by using HRTEM (JEM-2100, JEOL, Tokyo, Japan) at an accelerated voltage of 200 kV.
2.9. Estimation of Antioxidant Activity—DPPH Radical Scavenging Activity
The ability to scavenge the free radical DPPH of the ALE of P. odoratissimum, biosynthesized ZnO NPs and standard L-ascorbic acid at different concentrations ranging from 3125–100 μg mL−1 were performed using the Brand-Williams et al. method [46]. Briefly, 2 mL of the DPPH solution (Sigma-Aldrich, 3050 Spruce Street, St. Louis, MO 63103, USA) (25 mg L−1 in methanol) was added to 0.1 mL of different concentrations of each sample and standard L-ascorbic acid (3125–100 μg mL−1). After shaking vigorously for 1 min, the reaction mixture was maintained in the dark for 30 min at room temperature (35 ± 2 °C) and the absorbance was recorded at 517 nm using the U-2900 UV-Vis double beam spectrophotometer (Hitachi, Tokyo, Japan). Each measurement was taken in three replications. The free radical scavenging activity (FRSA) of each sample was expressed as percent inhibition of DPPH free radical and was calculated as:
% inhibition (% Anti-radical activity) = [(A control − A sample)/A control] × 100, where A is the absorbance. The IC50 values were measured from the relationship curve of FRSA versus concentrations of the respective sample curve.
2.10. Estimation of Antibacterial Activity
2.10.1. Bacteria Strains
The antibacterial effect of the biosynthesized ZnO NPs with P. odoratissimum ALE was established against two Gram-positive bacteria (GPB), Bacillus cereus (ATCC13753) and Staphylococcus aureus (ATCC8095), and two Gram-negative bacteria (GNB), Escherichia coli (ATCC25922) and Pseudomonas aeruginosa (ATCC10662). These four strains were acquired from the Microbiol. Dept., Fac. Agric., Fym. Univ., Egypt. The bacterial strains used were maintained in the Luria–Bertani (LB) agar at 30 °C for 24 h and then kept at 4 °C in a refrigerator. During this study, LB media was used for all bacterial cultures.
2.10.2. Antibacterial Assay
The antibacterial effect against the examined bacterial strains was determined using the agar disc diffusion method (ADDM) described by Bauer et al. [47]. In this method, three different ZnO NPs concentrations (10, 20 and 30 μg mL−1) and ALE (20 μg mL−1) were dissolved in ethanol and then used to fill sterilized Whatman filter paper discs of approximately 40 μL with the proper volume containing the tested ZnO NPs concentrations and ALE and left to totally dry. A disc containing only solvent was used as a negative control and a disc containing zinc acetate dihydrate was employed. A positive control gentamicin (10 μg mL−1) was used. Overnight bacterial cultures were prepared in LB broth for obtaining tested bacterial suspensions for the assay. The discs were then placed on the plates having the tested bacterial cultures and diluted to obtain about 1 × 10−7 colony-forming unit (CFU). The inoculated plates were incubated at 37 °C for 24 h and then the activity was assayed by measuring the inhibition diameter in millimeters (mm). All tests were performed in triplicate.
2.11. Estimation of Anti-inflammatory Activity
The human red blood cells (HRBCs)-membrane stabilization method (HRBCs-MSM) has been performed for the evaluation of in vitro anti-inflammatory activity according to the procedure outlined by Anosike et al. [48].
2.12. Statistical Analysis
All of the tests (antioxidant, antibacterial, and anti-inflammatory activity) were performed in triplicates, with the results provided as mean ± SD. Using the statistical software SPSS (SPSS version 21, IBM Corporation, Armonk, NY, USA), the statistical data were examined using the two-way ANOVA technique. The difference in significance was calculated at p < 0.05.
3. Results and Discussion
3.1. Qualitative Phytochemical Screening (QPS)
The results of the QPS of P. odoratissimum ALE are summarized in (Table 1), which displays the existence of saponins, phenolics and tannins, flavonoids, carbohydrates and/or glycosides and the absence of steroids, triterpenoids and alkaloids. These present compounds could be responsible for the bio-reduction of the metal salts into nanosize particles [49].

Table 1.
Qualitative phytochemical screening of P. odoratissimum ALE.
3.2. HPLC-Analysis
HPLC analysis of ALE indicates the presence of sixteen phenolic compounds in appropriate amounts: Gallic acid, Chlorogenic acid, Catechin, Methyl gallate, Caffeic acid, Syringic acid, Rutin, Ellagic acid, Coumaric acid, Ferulic acid, Naringenin, Daidzein, Quercetin, Cinnamic acid, Apigenin and Kaempferol (Table 2 and Figure 2, respectively), that may be responsible for the bio-reduction of the metal salts into ZnO-nanosize particles. Additionally, Gallic acid, Syringic acid, Chlorogenic acid, Ferulic acid, Naringenin, Ellagic acid, Rutin and Coumaric acid were found to be highly prevalent among several significant phenolic components identified. Both phenolic acids and flavonoids are known to be potent hydrogen donors [50], which are responsible for a variety of biological activities because of their functional (carboxyl and hydroxyl) groups. The amounts (µg/g) and structures of polyphenols are illustrated in Table 2 and Figure 3, respectively.

Table 2.
Polyphenolic compounds of P. odoratissimum ALE.


Figure 2.
HPLC chromatogram: (a) standard polyphenolic compounds; (b) ALE of P. odoratissimum.

Figure 3.
Chemical structures of polyphenolic compounds present in P. odoratissimum ALE.
3.3. Characterization of ZnO NPs
3.3.1. Visual Observation
The first essential indicator that confirms the biosynthesis of ZnO NPs is visual observation. When the Zn(CH3COO)2·2H2O, as a precursor for ZnO NPs, was added to the P. odoratissimum leaf extract, the color of the P. odoratissimum leaf extract was changed from light red to cream-colored precipitate (Figure 4). Similar color changes of synthesized ZnO NPs employing Hibiscus subdariffa leaf extract, from light red to cream-colored precipitate, were displayed by Bala et al. [16], confirming the biosynthesis of ZnO NPs.

Figure 4.
The visual observation of colour changes at 0 time (a) (P. odoratissimum ALE) and after 30 min (b) (P. odoratissimum ALE and (Zn(CH3COO)2·2H2O)).
3.3.2. UV-Vis Spectroscopy
To confirm the synthesis of ZnO NPs, UV/Vis spectrophotometry was performed in order to examine the optical characteristics of green synthesized ZnO NPs using P. odoratissimum ALE. The UV-Vis spectrum recorded the maximum absorbance peak at 370 nm as shown in Figure 5, which verified the synthesis of ZnO NPs via P. odoratissimum ALE, which is consistent with earlier studies by Senthilkumar et al. [51], who examined the ability of Tecona grandis (L.) ALE to synthesize ZnO NPs with surface plasmon resonance (SPR) at 370 nm. Additionally, there are no other peaks recorded in the spectrum which means that the biosynthesized ZnO NPs are a pure product. Furthermore, the high absorption band seen at 378 nm might be attributed to ZnO’s inherent band-gap absorption caused by electron transitions from the valence band (EV) to the conduction band (EC) (O2p–Zn3d) [52,53]. The formula for calculating the energy bandgap (EG) of ZnO NPs was used as follows:
EG = hc/λ

Figure 5.
UV/Vis spectrum of ZnO NPs biosynthesized using P. odoratissimum ALE.
Where h is Planck’s constant (6.626 × 10−34 Js), c is the velocity of light (3 × 108 m/s) and λ is the wavelength (378 nm). In total, 3.28 eV was found to be the bandgap energy of ZnO. The significant UV absorption of ZnO NPs demonstrates the product’s suitability for a variety of medicinal applications, including sun-screen protectors and antibacterial ointments [54].
3.3.3. Dynamic Light Scattering (DLS)
The Z-average diameter (nm) and PSD of the biosynthesized ZnO NPs were measured using the DLS technique. As shown in Figure 6A, the measurements demonstrated that the average size (nm) of the ZnO NPs with P. odoratissimum ALE was about 76 nm. The result obtained from the PSD profile of the ZnO nanoparticles revealed two notable peaks with intensities of 98.7% and 1.3%. Additionally, the ZnO NPs have a polydispersity index (PDI) of 0.241. This indicated that ZnO nanoparticles are very homogeneous and have a uniform size range [55]. This finding is completely compatible with Badran, Chen et al. and Putri et al. [56,57,58] who reported that PDI values of 0.3 and below are considered to be monodisperse. Because of the hydrodynamical shell, the DLS technique is known to produce significantly higher values than HRTEM size analyses. Additionally, the size of the hydrodynamical shell is influenced by particle structure, particle shape, and roughness [59].


Figure 6.
PSD (A) and ZP (B) of green synthesized P. odoratissimum-ZnO nanoparticles.
The surface charges and stability of biosynthesized ZnO NPs have been assessed through zeta potential (ZP) analysis. The ZP graph of ZnO nanoparticles is presented in (Figure 6B). As shown in Figure 6B, the ZP was found to be −19.3 mV which indicates the potential stability of the examined NPs [51]. As a result, the reducing agents (i.e., phenolic and flavonoid components) found in the leaf extract (LE) are probably responsible for the negative charge potential of the produced ZnO NPs. It also confirms that the produced substance contains substantial electrostatic forces [60].
3.3.4. FTIR Analysis of Biosynthesized ZnO NPs and P. odoratissimum ALE
The FTIR technique was used in order to detect possible FGs present in the ALE of P. odoratissimum that contribute to the reduction in and stabilization of ZnO NPs. Figure 7a,b represents the FTIR spectra of biosynthesized ZnO nanoparticles and P. odoratissimum leaf extract. The peaks of P. odoratissimum ALE and biosynthesized ZnO nanoparticles are displayed in Table 3. The broad stretch peak at 3409 cm−1 and 3417 cm−1 indicates the presence of an O-H stretch band for the extract and ZnO NPs which are corresponded to the O-H stretching of alcohol, phenolic and flavonoid constituents [61,62]. The low-intensity peaks that arise at 2923 cm−1 and 2920 cm−1 were assigned to –CH stretching vibration of the hydroxyl compounds [63,64]. The absorption peaks at 2356 cm−1 and 2356 cm−1 were ascribed to O=C=O (stretching vibration) [65]. The peaks observed at 1616 cm−1 and 1621 cm−1 indicate the stretching C=C vibration of the aromatic ring system [66,67]. The absorption peaks at 1400 cm−1 and 1403 cm−1 correspond to the C-N stretching vibration of amino acids [63]. The strong intensity peaks at 1068 cm−1 and 1072 cm−1 are due to the C-O stretching bond of the aromatic rings [67] and may also be related to phenols and flavonoids found in the P. odoratissimum ALE in Table 1. The bands at 852 cm−1 and 855 cm−1 are attributed to –CH stretching vibration of aromatics [64]. The absorption band observed at 435 cm−1 confirmed the successful formation of Metal-Oxygen (ZnO). The ZnO absorption peak obtained by FTIR analysis of biosynthesized ZnO NPs has been detected at wavelengths 436 cm−1 [51], 442 cm−1 [68], 450 cm−1 [69] and 485 cm−1 [70], in the range 400 to 500 cm−1 [71], which are consistent with our findings. The similarity of bands in both P. odoratissimum ALE and P. odoratissimum-synthesized ZnO NPs (Table 3) could be attributable to capped biomolecules on the surface of green synthesized ZnO nanoparticles.

Figure 7.
FTIR absorption spectra of (a) ZnO NPs and (b) ALE of P. odoratissimum.

Table 3.
FTIR spectra of biosynthesized ZnO NPs and P. odoratissimum ALE.
3.3.5. X-ray Diffraction (XRD) Analysis of ZnO NPs
The XRD pattern of biosynthesized ZnO NPs using ALE of P. odoratissimum is illustrated in Figure 8. The XRD diffraction peaks existed at 2θ angles of 31.85°, 34.55°, 36.35°, 47.69°, 56.75°, 63.09°, 66.56°, 68.17°, 69.29°, 72.87° and 77.21° corresponding to lattice planes (100), (002), (101), (102), (110), (103), (200), (112), (201), (004) and (202), respectively [72]. These peaks are in accordance with those of (JCPDS card No: 36-1451), which is indicating the confirmation of the hexagonal wurtzite structure of ZnO NPs formation [73]. The average crystalline size (ACS) of biosynthesized ZnO NPs was calculated using Deby-Scherrer’s formula [74] and the ACS of the ZnO NPs was estimated to be 14 nm, which is derived from the full width at half maximum (FWHM) of the most intense peak corresponding to (101) plane located at 36.35°. Furthermore, the XRD pattern revealed no additional peaks other than the characteristic ZnO peaks, confirming the purity of the produced ZnO NPs. Additionally, the narrow and strong diffraction peak clearly indicates that the ZnO NPs have an optimal crystalline structure [75,76].

Figure 8.
XRD pattern of biosynthesized ZnO NPs via P. odoratissimum L. ALE.
3.3.6. FE-SEM of ZnO NPs
The size and the morphology of the biosynthesized ZnO nanoparticles were imaged via FE-SEM (Figure 9), and the chemical composition of the biosynthesized ZnO nanoparticles was determined using EDX (Figure 10). The FE-SEM image demonstrated that the ZnO NPs were spherical and hexagonal in the morphology shape with good distribution. AN FE-SEM examination showed that the average size of ZnO NPs was 21.6 nm.


Figure 9.
FE-SEM image of biosynthesized ZnO NPs.

Figure 10.
EDX Spectrum of biosynthesized ZnO NPs.
3.3.7. Energy Dispersive X-ray Analysis (EDX) Spectrum of ZnO NPs
The elemental mapping of the EDX (Figure 10) verified that the examined sample displayed the elemental peaks of zinc and oxygen which are summarized in Table 4. The EDX analysis proved that the examined sample contained the biosynthesized ZnO NPs.

Table 4.
Elemental constituents of ZnO NPs.
3.3.8. HR-TEM of ZnO NPs
The high-resolution TEM analysis (Figure 11a–g) was carried out to confirm the formation of the biosynthesized ZnO NPs. Based on the results obtained, it can be concluded that the pure green ZnO NPs display hexagonal shapes with an average size of 34.12 nm (Figure 11i) and also clearly reveal lattice fringes without any distortion, indicating that ZnO NPs have high crystallinity. The selected area electron diffraction (SAED) (Figure 11h) pattern revealed a series of rings with bright spots, indicating that ZnO nanoparticles are crystalline in nature [74,76]. Additionally, the hexagonal wurtzite crystalline structure of ZnO NPs is also proven by the diffraction rings on the SAED image and the peaks in the XRD pattern.


Figure 11.
(a–g) HR-TEM images of biosynthesized ZnO NPs, (h) SAED pattern and (i) histogram of particle size distribution.
3.4. Antioxidant Activity
The antioxidant activity of ZnO NPs, the ALE of P. odoratissimum and L-ascorbic acid are shown in Figure 12. The results obtained show the DPPH scavenging activity of ZnO NPs, ALE and L-ascorbic acid at six different concentrations (3.125 to 100 μg mL−1) ranging from 10.78 to 76.14%, 23.05 to 89.92% and 14.70 to 83.02% respectively. The DPPH assay showed the scavenging effect of ZnO nanoparticles having an IC50 value of 28.11 ± 0.01 μg mL−1 when compared with the IC50 value of L-ascorbic acid (11.50 ± 0.03 μg mL−1) and aqueous extract (04.56 ± 0.02 μg mL−1). Additionally, the aqueous extract revealed a superior antioxidant potential to traditional reference L-ascorbic acid, which could be due to various bioactive constituents and the higher content of phenolics and flavonoids present in the P. odoratissimum ALE. Moreover, the IC50 value of P. odoratissimum ALE exhibited higher antioxidants than the aqueous extract of P. graveolens, which had an IC50 value of 16.59 μg mL−1 [77].

Figure 12.
DPPH FRSA of ZnO NPs, ALE and L-ascorbic acid at different concentrations.
Generally, phenolic and flavonoid compounds are almost present in all plants in varying proportions and have been reported to act as bio-reductants of metallic ions in an aqueous medium and display a wide range of biological activities such as antioxidant and antimicrobial activity [78]. Many studies have specified that various OH groups’ presence in phenolic and flavonoids are responsible for the formation and stabilization of metal and metal oxide nanoparticles [79,80,81].
As presented in Table 5, the total phenolic content (TPC) of P. odoratissimum ALE was found to be 21.93 ± 0.01 mg GAE/g of dried leaf extract, while the total flavonoid content (TFC) was recorded to be 17.11 ± 0.001 mg RE/g of dried leaf extract. From the above results, the ALE of P. odoratissimum possesses phytoconstituents that can be used in the formation, capping, stabilization and reduction of zinc acetate salt into ZnO NPs via the green route.

Table 5.
IC50, total phenolic (TP), and total flavonoid (TF) contents of P. odoratissimum ALE.
3.5. Antibacterial Activity
The antibacterial effect of the biosynthesized ZnO NPs was evaluated by disc diffusion assay against S. aureus (ATCC 8095), B. cereus (ATCC 13753) as GPB, and E. coli (ATCC 25922) and P. aeruginosa (ATCC10662) as GNB. The results are represented in Table 6 and Figure 13. Generally, the results revealed that the biosynthesized ZnO NPs using P. odoratissimum ALE possessed a significant antibacterial effect against all tested bacterial strains. The significant antibacterial zone of inhibition was recorded in S. aureus (28 ± 0.35 mm) followed by B. cereus (24 ± 0.14 mm), P. aeruginosa (21 ± 0.28 mm) and E. coli (16 ± 0.21 mm). ALE does not observe any zone of inhibition in the tested bacterial strains. Furthermore, compared to gentamycin as a positive control and ALE of P. odoratissimum, biosynthesized ZnO NPs displayed higher antibacterial activity. The antibacterial activities of ZnO NPs differ depending on the cell wall nature of GPB or GNB [82,83]. In the present study, the biosynthesized ZnO NPs showed higher antibacterial activity against GPB (S. aureus and B. cereus) compared to GNB (P. aeruginosa and E. coli). A similar trend was obtained by Vijayakumar et al. [10] who stated that ZnO NPs synthesized from Laurus nobilis leaf extract displayed greater antibacterial activity against GPB (S. aureus) than GNB (P. aeruginosa). This is maybe owing to the structure and the components of GPB (i.e., peptidoglycan layer) and may improve the ZnO NPs’ attachment to the cell wall, while the components of GNP avoid this attachment [84].

Table 6.
Evaluation of the antibacterial activity toward pathogenic bacteria.
Figure 13.
Antibacterial effects (zone of inhibition (mm)) at different concentrations of ZnO NPs (A: 10 μg mL−1; B: 20 μg mL−1; C: 30 μg mL−1 and D: standard) towards various pathogens.
Additionally, the results indicated that the inhibitory effect of biosynthesized ZnO NPs using P. odoratissimum leaf extract increased when the concentration of ZnO NPs was increased. This was in agreement with Gunalan et al. [85], who reported that increasing the concentration of ZnO NPs in discs and wells consistently increased the growth inhibition due to optimal NPs diffusion in the agar medium.
For the effect of ZnO NPs, there are some proposed bactericidal mechanisms (Figure 14) that have been suggested by scientists. Some suggested that the released Zn from ZnO NPs possess toxic properties that are leading to inhibiting a lot of bacterial cell activities such as bacterial metabolism, and enzyme activity resulting in cell bacterial death [86,87]. The other suggested mechanism is the formation of reactive oxygen species (ROS) that activates oxidative stress which subsequently leads to cell death [88,89]. Another proposed mechanism is the lethal activity of the ZnO NPs due to the attachment of the NPs to the bacterial cell membranes, and the accumulation inside the cytoplasm resulting in damaging the cell membrane integrity and loss of cell contents because of the leakage ending up with cell death [90].

Figure 14.
Various proposed mechanisms of ZnO NPs toxicity against bacteria [17].
3.6. Anti-inflammatory Activity
During times of inflammation, lysosomes lyse and release their component enzymes, resulting in a variety of disorders. Nonsteroidal anti-inflammatory drugs (NSAIDs) work by either blocking lysosomal enzyme release or stabilizing lysosomal membranes [91]. When RBCs are exposed to harmful substances such as hypotonic medium, heat, methyl salicylate (MeS) or phenylhydrazine (PhNHNH2), the membranes lyse, resulting in hemolysis and hemoglobin oxidation [92]. Because the membranes of HRBCs are similar to those of lysosomes [91], the inhibition of hypotonicity-induced RBCs membrane lysis was used as a measure of the mechanism of the anti-inflammatory effect of ZnO NPs and P. odoratissimum ALE.
From the results obtained in Table 7, the ZnO NPs and P. odoratissimum ALE have an anti-inflammatory effect that is concentration-dependent, with the percentage of protection increasing as the concentration of the samples increases. At the concentration of 1000 μg mL−1, the ZnO NPs significantly (p ≤ 0.05) produced 95.60% inhibition of RBC hemolysis, and it was comparable to the results achieved with standard indomethacin (Table 7). The hemolytic effect of the hypotonic solution is due to an excessive accumulation of fluid within the cell, which causes the cell membrane to rupture. Damage to the red cell membrane (RCM) increases the cell’s vulnerability to subsequent damage caused by free radical-induced lipid peroxidation [93]. During a time of increased permeability produced by inflammatory mediators, membrane stability prevents leaking the flow of serum protein and fluids into the tissues [94]. The ZnO NPs and ALE of P. odoratissimum maybe stabilized the RBC membrane by preventing the release of active mediators of inflammation and lytic enzymes. Furthermore, many studies have revealed that plant flavonoids have anti-inflammatory and antioxidant activity [95,96,97]. Their anti-inflammatory properties are thought to be owing to an inhibitory action on enzymes involved in the synthesis of the chemical mediators of inflammation and arachidonic acid metabolism [98,99].

Table 7.
Effect of the biosynthesized ZnO NPs and ALE of P. odoratissimum on hypotonicity-induced hemolysis of HRBCs.
4. Conclusions
This study presents the biosynthesized ZnO NPs for the first time using an ALE of P. odoratissimum via a simple green route. The biosynthesized ZnO NPs showed a characteristic Uv-Vis absorption peak at 370 nm. The XRD pattern also indicated the hexagonal pure Wurtzite structure. FE-SEM coupled with EDX, HR-TEM, FTIR and DLS, confirmed the formation of NPs with an average size of 34.12 nm as obtained from HR-TEM analysis. The DPPH assay revealed that ZnO NPs possess antioxidant activity with an IC50 value of 28.11 μg mL−1. Furthermore, ZnO NPs showed excellent antibacterial effects against both GNB and GPB. In addition, ZnO NPs were found to be more effective as anti-inflammatory via stabilizing the RBCs’ membrane in in vitro models. Our findings suggest the possibility of using the aqueous leaf extract of P. odoratissimum for synthesizing stable ZnO NPs. The biosynthesized ZnO NPs possess a significant antioxidant, antibacterial against foodborne pathogenic bacteria and anti-inflammatory activities that can be used as a safe and stable alternative to synthetic substances in the fields of pharmaceutical and biomedical research.
Author Contributions
Conceptualization, A.S.A. and A.M.H.A.M.; methodology, A.S.A. and A.M.H.A.M.; biosynthesis and all characterization, A.S.A. and A.M.H.A.M.; validation, A.S.A. and A.M.H.A.M.; data analyzation, A.S.A. and A.M.H.A.M., software.; A.S.A. and A.M.H.A.M., resources., A.S.A. and A.M.H.A.M., data interpretation., A.S.A. and A.M.H.A.M., writing—original draft preparation., A.S.A. and A.M.H.A.M., writing—review and editing., A.S.A., T.A.A.E.-M., A.O.B., S.S. and A.M.H.A.M., visualization, A.S.A. and A.M.H.A.M. All authors have read and agreed to the published version of the manuscript.
Funding
This research received no external funding.
Institutional Review Board Statement
Not applicable.
Informed Consent Statement
Not applicable.
Data Availability Statement
The data presented are included within the article.
Conflicts of Interest
The authors declare that they have no conflict of interest.
References
- Bhardwaj, A.; Sharma, G.; Gupta, S. Nanotechnology Applications and Synthesis of Graphene as Nanomaterial for Nanoelectronics. In Nanomaterials and Environmental Biotechnology; Bhushan, I., Singh, V., Tripathi, D., Eds.; Springer: Cham, Switzerland, 2020; pp. 251–269. [Google Scholar]
- Dash, D.K.; Panik, R.K.; Sahu, A.K.; Tripathi, V. Role of Nanobiotechnology in Drug Discovery Development and Molecular Diagnostic. In Applications of Nanobiotechnology; Stoytcheva, M., Zlatev, R., Eds.; IntechOpen: London, UK, 2020; pp. 37–43. [Google Scholar]
- Patil, M.P.; Kim, G.D. Eco-friendly approach for nanoparticles synthesis and mechanism behind antibacterial activity of silver and anticancer activity of gold nanoparticles. Appl. Microbiol. Biotechnol. 2017, 101, 79–92. [Google Scholar] [CrossRef] [PubMed]
- Phull, A.R.; Abbas, Q.; Ali, A.; Raza, H.; Zia, M.; Haq, I.U. Antioxidant cytotoxic and antimicrobial activities of green synthesized silver nanoparticles from crude extract of Bergenia ciliata. J. Pharm. Sci. 2016, 2, 31–36. [Google Scholar] [CrossRef]
- Khan, I.; Saeed, K.; Khan, I. Nanoparticles: Properties applications and toxicities. Arab. J. Chem. 2019, 12, 908–931. [Google Scholar] [CrossRef]
- Nilavukkarasi, M.; Vijayakumar, S.; Prathipkumar, S. Capparis zeylanica mediated bio-synthesized ZnO nanoparticles as antimicrobial photocatalytic and anti-cancer applications. Mater. Sci. Technol. 2020, 3, 335–343. [Google Scholar] [CrossRef]
- Zheng, X.; Yuhui, W.; Ling, S.; Arunachalam, C.; Sulaiman, A.; Liwei, F. Anticarcinogenic effect of zinc oxide nanoparticles synthesized from Rhizoma paridis saponins on Molt-4 leukemia cells. J. King Saud Univ. Sci. 2020, 32, 1865–1871. [Google Scholar]
- Waseem, A.; Divya, K. Green synthesis characterization and anti-microbial activities of ZnO nanoparticles using Euphorbia hirta leaf extract. J. King Saud Univ. Sci. 2020, 32, 2358–2364. [Google Scholar]
- Bekele, E.T.; Gonfa, B.A.; Zelekew, O.A.; Belay, H.H.; Sabir, F.K. Synthesis of titanium oxide nanoparticles using root extract of kniphofia foliosa as a template characterization and its application on drug resistance bacteria. J. Nanomater. 2020, 2020, 2817037. [Google Scholar] [CrossRef]
- Vijayakumar, S.; Vaseeharan, B.; Malaikozhundan, B.; Shobiya, M. Laurus nobilis leaf extract mediated green synthesis of ZnO nanoparticles: Characterization and biomedical applications. Biomed. Pharm. 2016, 84, 1213–1222. [Google Scholar] [CrossRef]
- Mauricio, M.D.; Guerra-Ojeda, S.; Marchio, P.; Valles, S.L.; Aldasoro, M.; Escribano-Lopez, I.; Herance, J.R.; Rocha, M.; Vila, J.M.; Victor, V.M. Nanoparticles in medicine: A focus on vascular oxidative stress. Oxid. Med. Cell Longev. 2018, 2018, 6231482. [Google Scholar] [CrossRef]
- Seyyed, M.; Tabrizi, H.M.; Behrouz, E.; Vahid, J. Biosynthesis of pure zinc oxide nanoparticles using Quince seed mucilage for photocatalytic dye degradation. J. Alloys Compd. 2020, 821, 153519–153527. [Google Scholar]
- Rasli, N.I.; Basri, H.; Harun, Z. Zinc oxide from Aloe vera extract: Two-level factorial screening of biosynthesis parameters. Heliyon 2020, 6, e03156. [Google Scholar] [CrossRef] [PubMed]
- Vijayakumar, S.; Arulmozhi, P.; Kumar, N.; Sakthivel, B.; Prathip Kumar, S.; Praseetha, P.K. Acalypha fruticose L. leaf extract mediated synthesis of ZnO nanoparticles: Characterization and antimicrobial activities. Mater. Today Proc. 2020, 23, 73–80. [Google Scholar] [CrossRef]
- Muthuvel, A.; Jothibas, M.; Manoharan, C. Effect of chemically synthesis compared to biosynthesized ZnO-NPs using Solanum nigrum leaf extract and their photocatalytic antibacterial and in vitro antioxidant activity. J. Environ. Chem. Eng. 2020, 8, 103705. [Google Scholar] [CrossRef]
- Niranjan, B.; Saha, S.; Chakraborty, M.; Das, S.; Basub, R.; Nandyc, P. Green synthesis of zinc oxide nanoparticles using Hibiscus subdariffa leaf extract: Effect of temperature on synthesis anti-bacterial activity and anti-diabetic activity. RSC Adv. 2015, 5, 4993–5003. [Google Scholar]
- Yusof, H.M.; Mohamad, R.; Zaidan, U.H.; Rahman, N.A.A. Microbial synthesis of zinc oxide nanoparticles and their potential application as an antimicrobial agent and a feed supplement in animal industry: A review. J. Anim. Sci. Biotechnol. 2019, 10, 1–22. [Google Scholar]
- Bandeira, M.; Giovanela, M.; Roesch-Ely, M.; Devine, D.; da Silva Crespo, J. Green synthesis of zinc oxide nanoparticles: A review of the synthesis methodology and mechanism of formation. Sustain. Chem. Pharm. 2020, 15, 100223. [Google Scholar] [CrossRef]
- Davar, F.; Majedi, A.; Mirzaei, A. Green synthesis of ZnO nanoparticles and its application in the degradation of some dyes. J. Am. Ceram. Soc. 2015, 98, 1739–1746. [Google Scholar] [CrossRef]
- Prasad, K.S.; Prasad, S.K.; Ansari, M.A.; Alzohairy, M.A.; Alomary, M.N.; AlYahya, S.; Shivamallu, C. Tumoricidal and bactericidal properties of ZnONPs synthesized using Cassia auriculata leaf extract. Biomolecules 2020, 10, 982. [Google Scholar] [CrossRef]
- Chaudhary, A.; Kumar, N.; Kumar, R.; Kumar, R. Antimicrobial activity of zinc oxide nanoparticles synthesized from Aloe vera peel extract. SN Appl. Sci. 2019, 1, 136. [Google Scholar] [CrossRef]
- Shekhawat, M.S.; Ravindran, C.P.; Manokari, M. Biogenic production of zinc oxide nanoparticles from aqueous extracts of Duranta erecta L. World Sci. News 2016, 28, 30. [Google Scholar]
- Mohammad, A.A.; Mahadevamurthy, M.; Daruka, P. Cinnamomum verum bark extract mediated green synthesis of ZnO nanoparticles and their antibacterial potentiality. Biomolecules 2020, 10, 134–336. [Google Scholar]
- Sharmila, G.; Muthukumaran, C.; Sandiya, K.S. Biosynthesis characterization and antibacterial activity of zinc oxide nanoparticles derived from Bauhinia tomentosa leaf extract. J. Nanostructure Chem. 2018, 8, 293–299. [Google Scholar] [CrossRef]
- Elumalai, K.; Velmurugan, S.; Ravi, K. Bio-approach: Plant mediated synthesis of ZnO nanoparticles and their catalytic reduction of methylene blue and antimicrobial activity. Adv. Powder Technol. 2015, 26, 1639–1651. [Google Scholar] [CrossRef]
- Elumalai, K.; Velmurugan, S.; Ravi, S.; Kathiravan, V.; Ashokkumar, S. Green synthesis of Zinc oxide nanoparticles using Moringa oleifera leaf extract and evaluation of its antimicrobial activity. Spectrochim. Spectrochim. Acta Part A Mol. Biomol. Spectrosc. 2015, 143, 158–164. [Google Scholar] [CrossRef]
- Handago, D.T.; Enyew, A.Z.; Bedasa, A.G. Effects of Azadirachta indica leaf extract capping agents on the synthesis of pure and Cu doped ZnO-nanoparticles: A green approach and microbial activity. Open Chem. J. 2019, 17, 246–465. [Google Scholar] [CrossRef]
- Haque, M.J.; Bellah, M.M.; Hassan, M.R.; Rahman, S. Synthesis of ZnO nanoparticles by two different methods & comparison of their structural antibacterial photocatalytic and optical properties. Nano Express 2020, 1, 010007. [Google Scholar]
- Suresh, D.; Shobharani, R.M.; Nethravathi, P.C.; Kumar, M.A.P.; Nagabhushana, H.; Sharma, S. Artocarpus gomezianus aided green synthesis of ZnO nanoparticles: Luminescence photocatalytic and antioxidant properties. Spectrochim. Spectrochim. Acta Part A Mol. Biomol. Spectrosc. 2015, 141, 128–164. [Google Scholar] [CrossRef]
- Solabomi, O.O.; Yasmine, A.; Muchen, Z. Green synthesis of zinc oxide nanoparticles using different plant extracts and their antibacterial activity against Xanthomonas oryzae pv. Oryzae. Artif. Cells Nanomed Biotechnol. 2019, 47, 341–352. [Google Scholar]
- Nash, K.M.; Ahmed, S. Nanomedicine in the ROS-Mediated Pathophysiology: Applications and Clinical Advances. Nanomed. Nanotechnol. Biol. Med. 2015, 11, 2033–2040. [Google Scholar] [CrossRef]
- Cragg, G.M.; Newman, D.J.; Snader, K.M. Natural Products in Drug Discovery and Development. J. Nat. Prod. 1997, 60, 52–60. [Google Scholar] [CrossRef]
- Wang, L.; Hu, C.; Shao, L. The Antimicrobial Activity of Nanoparticles: Present Situation and Prospects for the Future. Int. J. Nanomed. 2017, 12, 1227. [Google Scholar] [CrossRef] [PubMed]
- Bown, D. The Royal Horticultural Society Encyclopedia of Herbs & Their Uses; Dorling Kindersley Limited: London, UK, 1995. [Google Scholar]
- Moutaouafiq, S.; Farah, A.; Ez zoubi, Y.; Ghanmi, M.; Satrani, B.; Bousta, D. Antifungal activity of Pelargonium graveolens essential oil and its fractions against wood decay fungi. J. Essent. Oil-Bear Plants 2019, 22, 1104–1114. [Google Scholar] [CrossRef]
- Carmen, G.; Hancu, G. Antimicrobial and antifungal activity of Pelargonium roseum essential oils. Adv. Pharm. Bull. 2014, 4, 511. [Google Scholar] [PubMed]
- Ben Slima, A.; Ali, M.B.; Barkallah, M.; Traore, A.I.; Boudawara, T.; Allouche, N.; Gdoura, R. Antioxidant properties of Pelargonium graveolens L’Her essential oil on the reproductive damage induced by deltamethrin in mice as compared to alpha-tocopherol. Lipids Health Dis. 2013, 12, 30. [Google Scholar] [CrossRef]
- Mnif, W.; Dhifi, W.; Jelali, N.; Baaziz, H.; Hadded, A.; Hamdi, N. Characterization of leaves essential oil of Pelargonium graveolens originating from Tunisia: Chemical composition antioxidant and biological activities. J. Essent. Oil-Bear Plants 2011, 14, 761–769. [Google Scholar] [CrossRef]
- Kolodziej, H. Traditionally used Pelargonium species: Chemistry and biological activity of umckaloabo extracts and their constituents. Curr. Top. Phytochem. 2000, 3, 77–93. [Google Scholar]
- Abdelbaky, A.S.; Diab, Y.M. Effect of various extraction methods and solvent types on yield phenolic and flavonoid content and antioxidant activity of Spathodea nilotica leaves. Egypt J. Chem. 2021, 64, 7483–7489. [Google Scholar] [CrossRef]
- Harbone, J.B. Phytochemical Methods; Chapman and Hall: London, UK, 1998; pp. 117–119. [Google Scholar]
- Farnsworth, N.R. Biological and phytochemical screening of plants. J. Pharm. Sci. 1966, 55, 225–276. [Google Scholar] [CrossRef]
- Rangari, V.D. Pharmacognosy and Phytochemistry; Carrier Publication: Nashik, Indian, 2002; p. 132. [Google Scholar]
- Yu, L.; Haley, S.; Perret, J.; Harris, M.; Wilson, J.; Qian, M. Free radical scavenging properties of wheat extracts. J. Agric. Food Chem. 2002, 50, 1619–1624. [Google Scholar] [CrossRef]
- Lamaison, J.L.C.; Carnet, A. Contents in main flavonoid compounds of Crataegus monogyna Jacq. and Crataegus laevigata (Poiret) D.C. flowers and leaves at different plant development stages. Pharm. Acta Helv. 1990, 65, 315–320. [Google Scholar]
- Brand-Williams, W.; Cuvelier, M.E.; Berset, C. Use of a free radical method to evaluate antioxidant activity. Lebensm Wissenchaft Technol. 1995, 28, 25–30. [Google Scholar] [CrossRef]
- Bauer, A.W.; Kirby, M.M.; Sherris, J.C.; Turck, M. Antibiotic susceptibility testing by a standardized single disk method. Amr. J. Clin. Pathol. 1966, 45, 493–496. [Google Scholar] [CrossRef]
- Anosike, C.A.; Obidoa, O.; Ezeanyika, L.U. Membrane stabilization as a mechanism of the anti-inflammatory activity of methanol extract of garden egg (Solanum aethiopicum). DARU J. Pharm. Sci. 2012, 20, 76. [Google Scholar] [CrossRef] [PubMed]
- Iravani, S.; Korbekandi, H.; Mirmohammadi, S.V.; Zolfaghari, B. Synthesis of silver nanoparticles: Chemical physical and biological methods. Res. Pharm. Sci. 2014, 9, 385–406. [Google Scholar] [PubMed]
- Abdelbaky, A.S.; Mohamed, A.M.H.A.; Alharthi, S.S. Antioxidant and Antimicrobial Evaluation and Chemical Investigation of Rosa Gallica var. aegyptiaca Leaf Extracts. Molecules 2021, 26, 6498. [Google Scholar] [CrossRef]
- Senthilkumar, N.; Nandhakumar, E.; Priya, P.; Soni, D.; Vimalan, M.; Potheher, I.V. Synthesis of ZnO nanoparticles using leaf extract of Tectona grandis (L.) and their anti-bacterial anti-arthritic anti-oxidant and in vitro cytotoxicity activities. New J. Chem. 2017, 41, 10347–10356. [Google Scholar] [CrossRef]
- Zak, A.K.; Majid, W.A.; Mahmoudian, M.R.; Darroudi, M.; Yousefi, R. Starch-stabilized synthesis of ZnO nanopowders at low temperature and optical properties study. Adv. Powder Technol. 2013, 24, 618–624. [Google Scholar]
- Zak, A.K.; Yousefi, R.; Abd Majid, W.H.; Muhamad, M.R. Facile synthesis and X-ray peak broadening studies of Zn1− xMgxO nanoparticles. Ceram Int. 2012, 38, 2059–2064. [Google Scholar]
- Suresh, D.; Nethravathi, P.C.; Rajanaika, H.; Nagabhushana, H.; Sharma, S.C. Green synthesis of multifunctional zinc oxide (ZnO) nanoparticles using Cassia fistula plant extract and their photodegradative antioxidant and antibacterial activities. Mater. Sci. Semicond. Process. 2015, 31, 446–454. [Google Scholar] [CrossRef]
- Akbar, N.; Aslam, Z.; Siddiqui, R.; Shah, M.R.; Khan, N.A. Zinc oxide nanoparticles conjugated with clinically-approved medicines as potential antibacterial molecules. AMB Express 2021, 11, 104. [Google Scholar] [CrossRef]
- Badran, M. Formulation and in vitro evaluation of flufenamic acid loaded deformable liposome for improved skin delivery. Dig. J. Nanomater. Biostruct. 2014, 9, 83–91. [Google Scholar]
- Chen, M.; Liu, X.; Fahr, A. Skin penetration and deposition of carboxyfluorescein and temoporfin from different lipid vesicular systems: In vitro study with finite and infinite dosage application. Int. J. Pharm. 2011, 408, 223–234. [Google Scholar] [CrossRef] [PubMed]
- Putri, D.C.; Dwiastuti, R.; Marchaban, M.; Nugroho, A.K. Optimization of mixing temperature and sonication duration in liposome preparation. J. Pharm. Sci. Commun. 2017, 14, 79–85. [Google Scholar] [CrossRef]
- Kätzel, U.; Vorbau, M.; Stintz, M.; Gottschalk-Gaudig, T.; Barthel, H. Dynamic light scattering for the characterization of polydisperse fractal systems: II. Relation between structure and DLS results. Part. Part. Syst. Charact. 2008, 25, 19–30. [Google Scholar] [CrossRef]
- Kokila, K.; Elavarasan, N.; Sujatha, V. Diospyros montana leaf extract-mediated synthesis of selenium nanoparticles and their biological applications. New J. Chem. 2017, 41, 7481–7490. [Google Scholar] [CrossRef]
- Jafarirad, S.; Mehrabi, M.; Divband, B.; Kosari-Nasab, M. Biofabrication of zinc oxide nanoparticles using fruit extract of Rosa canina and their toxic potential against bacteria: A mechanistic approach. Mater. Sci. Eng. C 2016, 59, 296–302. [Google Scholar] [CrossRef] [PubMed]
- Awwad, A.M.; Albiss, B.; Ahmad, A.L. Green synthesis characterization and optical properties of zinc oxide nanosheets using Olea europea leaf extract. Adv. Mater. Lett. 2014, 5, 520–524. [Google Scholar] [CrossRef]
- El-Belely, E.F.; Farag, M.; Said, H.A.; Amin, A.S.; Azab, E.; Gobouri, A.A.; Fouda, A. Green synthesis of zinc oxide nanoparticles (ZnO-NPs) using Arthrospira platensis (Class: Cyanophyceae) and evaluation of their biomedical activities. Nanomater 2021, 11, 95. [Google Scholar] [CrossRef]
- Pavithra, G. Leonotis nepetifolia mediated eco-friendly synthesis of zno nps: Photocatalytic antioxidant activities and their applications to nano-composite electrode material for supercapacitor. Heliyon 2021. preprint. [Google Scholar] [CrossRef]
- Jamdagni, P.; Poonam, K.; Rana, J.S. Green synthesis of zinc oxide nanoparticles using flower extract of Nyctanthes arbortristis and their antifungal activity. J. King Saud Univ. Sci. 2018, 30, 168–175. [Google Scholar] [CrossRef]
- Yuvakkumar, R.; Suresh, J.; Saravanakumar, B.; Nathanael, A.J.; Hong, S.I.; Rajendran, V. Rambutan peels promoted biomimetic synthesis of bioinspired zinc oxide nanochains for biomedical applications. Spectrochim. Spectrochim. Acta Part A Mol. Biomol. Spectrosc. 2015, 137, 250–258. [Google Scholar] [CrossRef] [PubMed]
- Alamdari, S.; Sasani Ghamsari, M.; Lee, C.; Han, W.; Park, H.H.; Tafreshi, M.J.; Ara, M.H.M. Preparation and characterization of zinc oxide nanoparticles using leaf extract of Sambucus ebulus. Appl. Sci. 2020, 10, 3620. [Google Scholar] [CrossRef]
- Nagarajan, S.; Arumugam Kuppusamy, K. Extracellular synthesis of zinc oxide nanoparticle using seaweeds of gulf of Mannar. India J. Nanobiotechnol. 2013, 11, 39. [Google Scholar] [CrossRef] [PubMed]
- Khari, S.; Jamzad, M.; Kabiri Fard, H. Green synthesis of zinc oxide nanoparticles: A comparison. Green Chem. Lett. Rev. 2019, 12, 19–24. [Google Scholar]
- Buazar, F.; Bavi, M.; Kroushawi, F.; Halvani, M.; Khaledi-Nasab, A.; Hossieni, S.A. Potato extract as reducing agent and stabilizer in a facile green one-step synthesis of ZnO nanoparticles. J. Exp. Nanosci. 2016, 11, 175–184. [Google Scholar] [CrossRef]
- Zhang, G.; Shen, X.; Yang, Y. Facile synthesis of monodisperse porous ZnO spheres by a soluble starch-assisted method and their photocatalytic activity. J. Phys. Chem. C 2011, 115, 7145–7152. [Google Scholar] [CrossRef]
- Albertsson, J.; Abrahams, S.C.; Kvick, Å. Atomic displacement anharmonic thermal vibration expansivity and pyroelectric coefficient thermal dependences in ZnO. Acta Crystallogr. B Struct. Sci. 1989, 45, 34–40. [Google Scholar] [CrossRef]
- Venkateasan, A.; Prabakaran, R.; Sujatha, V. Phytoextract-mediated synthesis of zinc oxide nanoparticles using aqueous leaves extract of Ipomoea pescaprae (L). R. br revealing its biological properties and photocatalytic activity. Nanotechnol. Environ. Eng. 2017, 2, 8. [Google Scholar] [CrossRef]
- Patterson, A.L. The Scherrer formula for X-ray particle size determination. Phys. Rev. 1939, 56, 978. [Google Scholar] [CrossRef]
- Barzinjy, A.A.; Azeez, H.H. Green synthesis and characterization of zinc oxide nanoparticles using Eucalyptus globulus Labill. leaf extract and zinc nitrate hexahydrate salt. SN Appl. Sci. 2020, 2, 991. [Google Scholar] [CrossRef]
- Khoshhesab, Z.M.; Sarfaraz, M.; Asadabad, M.A. Preparation of ZnO nanostructures by chemical precipitation method. Synth. React. Inorg. M 2011, 41, 814–819. [Google Scholar] [CrossRef]
- Boukhris, M.; Simmonds, M.S.; Sayadi, S.; Bouaziz, M. Chemical composition and biological activities of polar extracts and essential oil of rose-scented geranium Pelargonium graveolens. Phytother. Res. 2013, 27, 1206–1213. [Google Scholar] [CrossRef] [PubMed]
- Luo, F.; Yang, F.; Chen, D.; Megharaj, Z.; Naidu, R. One-step green synthesis of bimetallic Fe/Pd nanoparticles used to degrade Orange II. J. Hazard Mater. 2016, 303, 145–153. [Google Scholar] [CrossRef]
- Weng, X.; Guo, M.; Luo, F.; Chen, Z. One-step green synthesis of bimetallic Fe/Ni nanoparticles by eucalyptus leaf extract: Biomolecules identification characterization and catalytic activity. Chem. Eng. J. 2017, 308, 904–911. [Google Scholar] [CrossRef]
- Mittal, A.K.; Chisti, Y.; Banerjee, U.C. Synthesis of metallic nanoparticles using plant extracts. Biotechnol. Adv. 2013, 31, 346–356. [Google Scholar] [CrossRef]
- Aoki, K.; Chen, J.; Yang, N.; Nagasawa, H. Charge-transfer reactions of silver stearate-coated nanoparticles in suspensions. Langmuir 2003, 19, 9904–9909. [Google Scholar] [CrossRef]
- Sathiyavimal, S.; Vasantharaj, S.; Bharathi, D.; Saravanan, M.; Manikandan, E.; Kumar, S.S.; Pugazhendhi, A. Biogenesis of copper oxide nanoparticles (CuONPs) using Sida acuta and their incorporation over cotton fabrics to prevent the pathogenicity of gram negative and gram positive bacteria. J. Photochem. Photobiol. B Biol. 2018, 188, 126–134. [Google Scholar] [CrossRef]
- Bharathi, D.; Vasantharaj, S.; Bhuvaneshwari, V. Green synthesis of silver nanoparticles using Cordia dichotoma fruit extract and its enhanced antibacterial anti-biofilm and photo catalytic activity. Mater. Res. Express 2018, 5, 055404. [Google Scholar] [CrossRef]
- Getie, S.; Belay, A.; Chandra Reddy, A.R.; Belay, Z. Synthesis and characterizations of zinc oxide nanoparticles for antibacterial applications. J. Nanomed. Nanotechno. 2017, 8, 71–80. [Google Scholar]
- Gunalan, S.; Sivaraj, R.; Rajendran, V. Green synthesized ZnO nanoparticles against bacterial and fungal pathogens. Prog. Nat. Sci. 2012, 22, 693–700. [Google Scholar] [CrossRef]
- Yang, Z.; Xie, C. Zn2+ release from zinc and zinc oxide particles in simulated uterine solution. Colloids Surf. B 2006, 47, 140–145. [Google Scholar] [CrossRef]
- Soren, S.; Kumar, S.; Mishra, S.; Jena, P.K.; Verma, S.K.; Parhi, P. Evaluation of antibacterial and antioxidant potential of the zinc oxide nanoparticles synthesized by aqueous and polyol method. Microb. Pathog. 2018, 119, 145–151. [Google Scholar] [CrossRef] [PubMed]
- Nair, S.; Sasidharan, A.; Divya Rani, V.V.; Menon, D.; Nair, S.; Manzoor, K.; Raina, S. Role of size scale of ZnO nanoparticles and microparticles on toxicity toward bacteria and osteoblast cancer cells. J. Mater. Sci. Mater. Med. 2009, 20, 235–241. [Google Scholar] [CrossRef]
- Agarwal, H.; Menon, S.; Kumar, S.V.; Rajeshkumar, S. Mechanistic study on antibacterial action of zinc oxide nanoparticles synthesized using green route Chem-Biol. Interact 2018, 286, 60–70. [Google Scholar] [CrossRef] [PubMed]
- Jayaseelan, C.; Rahuman, A.A.; Kirthi, A.V.; Marimuthu, S.; Santhoshkumar, T.; Bagavan, A.; Rao, K.B. Novel microbial route to synthesize ZnO nanoparticles using Aeromonas hydrophila and their activity against pathogenic bacteria and fungi. Spectrochim. Acta Part A Mol. Biomol. Spectrosc. 2012, 90, 78–84. [Google Scholar] [CrossRef] [PubMed]
- Mounnissamy, V.M.; Kavimani, S.; Balu, V.; Quine, S.D. Evaluation of Anti-inflammatory and Membrane stabilizing property of Ethanol Extract of Cansjera rheedii J. Gmelin. (Opiliaceae). Iran J. Pharmacol. Ther. 2007, 6, 235–237. [Google Scholar]
- Ferrali, M.; Signorini, C.; Ciccoli, L.; Comporti, M. Iron release and membrane damage in erythrocytes exposed to oxidizing agents phenylhydrazine divicine and isouramil. Biochem. J. 1992, 285, 295–301. [Google Scholar] [CrossRef]
- Halliwell, B.; Whiteman, M. Measuring reactive species and oxidative damage in vivo and in cell culture: How should you do it and what do the results mean. Br. J. Pharmacol. 2004, 142, 231–255. [Google Scholar] [CrossRef]
- Chaitanya, R.; Sandhya, S.; David, B.; Vinod, K.R.; Murali, S. HRBC Membrane Stabilizing Property of Roor Stem and Leaf of Glochidion velutinum. Int. J. Res. Pharmaceut. Biomed. Sci. 2011, 2, 256–259. [Google Scholar]
- Middleton, J.R.E.; Kandaswami, C. Effects of flavonoids on immune and inflammatory cell functions. Biochem. Pharmacol. 1992, 43, 1167–1179. [Google Scholar] [CrossRef]
- Read, M.A. Flavonoids: Naturally occurring anti-inflammatory agents. Am. J. Pathol. 1995, 147, 235. [Google Scholar] [PubMed]
- Halliwell, B.; Rafter, J.; Jenner, A. Health promotion by flavonoids tocopherols tocotrienols and other phenols: Direct or indirect effects? Antioxidant or not? Am. J. Clin. Nutr. 2005, 81, 268S–276S. [Google Scholar] [CrossRef] [PubMed]
- Owoyele, V.B.; Oloriegbe, Y.Y.; Balogun, E.A.; Soladoye, A.O. Analgesic and anti-inflammatory properties of Nelsonia canescens leaf extract. J. Ethnopharmacol. 2005, 99, 153–156. [Google Scholar] [CrossRef] [PubMed]
- Metowogo, K.; Agbonon, A.; Eklu-Gadegbeku, K.; Aklikokou, A.K.; Gbeassor, M. Anti-ulcer and anti-inflammatory effects of hydroalcohol extract of Aloe buettneri A. Berger (Lilliaceae). Trop. J. Pharm. Res. 2008, 7, 907–912. [Google Scholar] [CrossRef][Green Version]
Publisher’s Note: MDPI stays neutral with regard to jurisdictional claims in published maps and institutional affiliations. |
© 2022 by the authors. Licensee MDPI, Basel, Switzerland. This article is an open access article distributed under the terms and conditions of the Creative Commons Attribution (CC BY) license (https://creativecommons.org/licenses/by/4.0/).


















